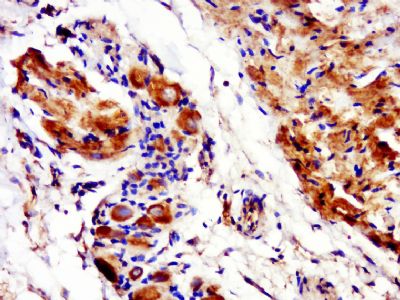
产品细节图片1

相关产品推荐更多 >
万千商家帮你免费找货
0 人在求购买到急需产品
- 详细信息
- 文献和实验
- 技术资料
- 供应商:
上海康朗生物科技有限公司
- 库存:
大量
- 目录编号:
kl-3098R
- 克隆性:
多克隆
- 抗原来源:
Rabbit
- 保质期:
12个月
- 抗体英文名:
Phospho-Connexin 43 (Ser368) antibody
- 抗体名:
磷酸化Connexin 43蛋白抗体
- 宿主:
Rabbit
- 适应物种:
Human, Mouse, Rat, Dog, Cow, Monkey,
- 免疫原:
KLH conjugated Synthesised phosphopeptide derived from human Connexin 43 around the phosphorylation site of Ser368:RA(p-S)SR
- 亚型:
IgG
- 形态:
冻干粉或液体
- 应用范围:
ELISA=1:500-1000 IHC-P=1:400-800 IHC-F=1:400-800 Flow-Cyt=1μg /test IF=1:100-500
- 浓度:
1mg/ml
- 保存条件:
-20 °C
- 规格:
100ul
| 中文名称 | 磷酸化Connexin 43蛋白抗体 |
| 别 名 | Connexin 43(phospho-Ser368); Connexin 43(phospho Ser368); Connexin 43(phospho S368); Connexin 43; Connexin43v Cx 43v CX43; DFNB38; Gap junction 43 kDa heart protein;Connexin-43; Gap junction alpha 1 protein; Gap junction protein alpha 1 43kDa (connexin 43); Gap junction protein alpha 1 43kDa; Gap junction protein alpha like; GJA 1; GJA1; GJA-1; GJAL; HGNC:4282; HGNC:8112; Oculodentodigital dysplasia; ODD; ODOD; SDTY3; Syndactyly type III; CXA1_HUMAN. |
| 规格价格 | 100ul/1580元 购买 大包装/询价 |
| 说 明 书 | 100ul |
| 产品类型 | 磷酸化抗体 |
| 研究领域 | 心血管 细胞生物 神经生物学 信号转导 细胞粘附分子 |
| 抗体来源 | Rabbit |
| 克隆类型 | Polyclonal |
| 交叉反应 | Human, Mouse, Rat, Dog, Cow, Monkey, |
| 产品应用 | ELISA=1:500-1000 IHC-P=1:400-800 IHC-F=1:400-800 Flow-Cyt=1μg /test IF=1:100-500 (石蜡切片需做抗原修复) not yet tested in other applications. optimal dilutions/concentrations should be determined by the end user. |
| 分 子 量 | 43kDa |
| 细胞定位 | 细胞膜 |
| 性 状 | Lyophilized or Liquid |
| 浓 度 | 1mg/ml |
| 免 疫 原 | KLH conjugated Synthesised phosphopeptide derived from human Connexin 43 around the phosphorylation site of Ser368:RA(p-S)SR |
| 亚 型 | IgG |
| 纯化方法 | affinity purified by Protein A |
| 储 存 液 | 0.01M TBS(pH7.4) with 1% BSA, 0.03% Proclin300 and 50% Glycerol. |
| 保存条件 | Store at -20 °C for one year. Avoid repeated freeze/thaw cycles. The lyophilized antibody is stable at room temperature for at least one month and for greater than a year when kept at -20°C. When reconstituted in sterile pH 7.4 0.01M PBS or diluent of antibody the antibody is stable for at least two weeks at 2-4 °C. |
| PubMed | PubMed |
| 产品介绍 | background: This gene is a member of the connexin gene family. The encoded protein is a component of gap junctions, which are composed of arrays of intercellular channels that provide a route for the diffusion of low molecular weight materials from cell to cell. The encoded protein is the major protein of gap junctions in the heart that are thought to have a crucial role in the synchronized contraction of the heart and in embryonic development. A related intronless pseudogene has been mapped to chromosome 5. Mutations in this gene have been associated with oculodentodigital dysplasia and heart malformations. [provided by RefSeq]. Function: Gap junction protein that acts as a regulator of bladder capacity. A gap junction consists of a cluster of closely packed pairs of transmembrane channels, the connexons, through which materials of low MW diffuse from one cell to a neighboring cell. May play a critical role in the physiology of hearing by participating in the recycling of potassium to the cochlear endolymph. Negative regulator of bladder functional capacity: acts by enhancing intercellular electrical and chemical transmission, thus sensitizing bladder muscles to cholinergic neural stimuli and causing them to contract. Subunit: A connexon is composed of a hexamer of connexins. Interacts (via C-terminus) with TJP1. Interacts (via C-terminus) with SRC (via SH3 domain). Interacts with UBQLN4. Interacts with SGSM3. Interacts with KIAA1432/CIP150. Interacts with CNST and CSNK1D. Subcellular Location: Cell membrane; Multi-pass membrane protein. Cell junction, gap junction. Tissue Specificity: Expressed in the heart and fetal cochlea. Post-translational modifications: Phosphorylated at Ser-368 by PRKCG; phosphorylation induces disassembly of gap junction plaques and inhibition of gap junction activity. Phosphorylation at Ser-325, Ser-328 and Ser-330 by CK1 modulates gap junction assembly. DISEASE: Defects in GJA1 are the cause of autosomal dominant oculodentodigital dysplasia (ODDD) [MIM:164200]; also known as oculodentoosseous dysplasia. ODDD is a highly penetrant syndrome presenting with craniofacial (ocular, nasal, dental) and limb dysmorphisms, spastic paraplegia, and neurodegeneration. Craniofacial anomalies tipically include a thin nose with hypoplastic alae nasi, small anteverted nares, prominent columnella, and microcephaly. Brittle nails and hair abnormalities of hypotrichosis and slow growth are present. Ocular defects include microphthalmia, microcornea, cataracts, glaucoma, and optic atrophy. Syndactyly type 3 and conductive deafness can occur in some cases. Cardiac abnormalities are observed in rare instances. Similarity: Belongs to the connexin family. Alpha-type (group II) subfamily. SWISS: P17302 Gene ID: 2697 Database links: Entrez Gene: 2697 Human Entrez Gene: 281193 Cow Entrez Gene: 403418 Dog Entrez Gene: 14609 Mouse Entrez Gene: 24392 Rat Omim: 121014 Human SwissProt: P18246 Cow SwissProt: Q6S9C0 Dog SwissProt: P17302 Human SwissProt: P23242 Mouse SwissProt: Q6TYA7 Rabbit SwissProt: P08050 Rat Unigene: 74471 Human Unigene: 378921 Mouse Unigene: 10346 Rat Important Note: This product as supplied is intended for research use only, not for use in human, therapeutic or diagnostic applications. 间隙连接蛋白-43(Gap junction alpha-1 protein; GJA-1; (Vascular smooth muscle connexin-43))是构成细胞间的通道,小分子成份可以借此在细胞间扩散。Connexin-43也是心肌缝隙连接的主要蛋白之一。 此外,星形细胞、成纤维细胞、平滑肌和肾等组织也有表达Connexin 43. |
| 产品图片 | Paraformaldehyde-fixed, paraffin embedded (mouse placenta); Antigen retrieval by boiling in sodium citrate buffer (pH6.0) for 15min; Block endogenous peroxidase by 3% hydrogen peroxide for 20 minutes; Blocking buffer (normal goat serum) at 37°C for 30min; Antibody incubation with (p-Connexin 43) Polyclonal Antibody, Unconjugated (bs-3098R) at 1:400 overnight at 4°C, followed by a conjugated secondary (sp-0023) for 20 minutes and DAB staining.  Blank control: Mouse Kidney (fixed with 2% paraformaldehyde for 10 min at 37℃). Primary Antibody:Rabbit Anti-Phospho-Connexin 43 (Ser368) antibody (bs-3098R,Green); Dilution: 1μg in 100 μL 1X PBS containing 0.5% BSA; Isotype Control Antibody: Rabbit IgG(orange) ,used under the same conditions; Secondary Antibody: Goat anti-rabbit IgG-FITC(white blue), Dilution: 1:200 in 1 X PBS containing 0.5% BSA. |
风险提示:丁香通仅作为第三方平台,为商家信息发布提供平台空间。用户咨询产品时请注意保护个人信息及财产安全,合理判断,谨慎选购商品,商家和用户对交易行为负责。对于医疗器械类产品,请先查证核实企业经营资质和医疗器械产品注册证情况。
 文献和实验
文献和实验Analysis of Connexin 43 Expression on Keratinocytes Using Flow Cytometry
of differentiation. Quantitative data for the differential expression of epitopes on single cells can be obtained using a flow cytometer. Simultaneous analysis of two intracellular epitopes, keratin 14 and connexin 43, using flow cytometry after keratinocyte
Lanthanide-Based Upconversion Nanoparticles for Connexin-Targeted Imaging in Co-cultures
. It was of interest to use connexin 43 gap junction protein-specific antibody on UCNs to target cardiac cell such as H9c2 and co-culture of bone marrow stem cells and H9c2.
Using Phospho‐Motif Antibodies to Determine Kinase Substrates
comprising both the phosphorylated residue and the surrounding residues that determine kinase specificity, with degenerate residues taking up the remaining positions. Currently, several categories of phospho?motif antibody are commercially available
 技术资料
技术资料暂无技术资料 索取技术资料









